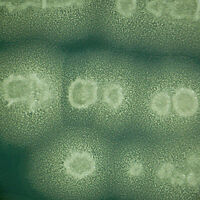

Maranello
- Bacillus subtilis
- Beneficial bacteria
Testimonials
Downloads
-
Promueve y estimula el crecimiento vegetal debido a:
- Secreción de moléculas biológicamente activas (aminoácidos, péptidos fitohormonas).
- Estimulación del sistema de defensa de la planta.
- Colonización de la raíz, generando una barrera física que protege la misma del ataque de microorganismos fitopatógenos.
- Jump to: